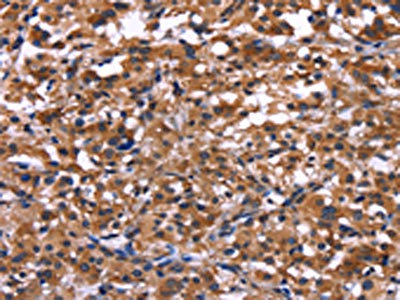

-
中文名稱:IL1A兔多克隆抗體
-
貨號:CSB-PA107052
-
規格:¥1100
-
圖片:
-
The image on the left is immunohistochemistry of paraffin-embedded Human thyroid cancer tissue using CSB-PA107052(IL1A Antibody) at dilution 1/40, on the right is treated with fusion protein. (Original magnification: ×200)
-
The image on the left is immunohistochemistry of paraffin-embedded Human liver cancer tissue using CSB-PA107052(IL1A Antibody) at dilution 1/40, on the right is treated with fusion protein. (Original magnification: ×200)
-
-
其他:
產品詳情
-
Uniprot No.:
-
基因名:
-
別名:BAF antibody; FAF antibody; Hematopoietin 1 antibody; Hematopoietin-1 antibody; IL 1 alpha antibody; IL 1A antibody; IL-1 alpha antibody; Il-1a antibody; IL1 ALPHA antibody; IL1 antibody; IL1A antibody; IL1A_HUMAN antibody; IL1F1 antibody; Interleukin 1 alpha antibody; Interleukin-1 alpha antibody; Interleukin1 alpha antibody; LAF antibody; LEM antibody; Preinterleukin 1 alpha antibody; Pro interleukin 1 alpha antibody
-
宿主:Rabbit
-
反應種屬:Human
-
免疫原:Fusion protein of Human IL1A
-
免疫原種屬:Homo sapiens (Human)
-
標記方式:Non-conjugated
-
抗體亞型:IgG
-
純化方式:Antigen affinity purification
-
濃度:It differs from different batches. Please contact us to confirm it.
-
保存緩沖液:-20°C, pH7.4 PBS, 0.05% NaN3, 40% Glycerol
-
產品提供形式:Liquid
-
應用范圍:ELISA,IHC
-
推薦稀釋比:
Application Recommended Dilution ELISA 1:2000-1:5000 IHC 1:50-1:200 -
Protocols:
-
儲存條件:Upon receipt, store at -20°C or -80°C. Avoid repeated freeze.
-
貨期:Basically, we can dispatch the products out in 1-3 working days after receiving your orders. Delivery time maybe differs from different purchasing way or location, please kindly consult your local distributors for specific delivery time.
-
用途:For Research Use Only. Not for use in diagnostic or therapeutic procedures.
相關產品
靶點詳情
-
功能:Produced by activated macrophages, IL-1 stimulates thymocyte proliferation by inducing IL-2 release, B-cell maturation and proliferation, and fibroblast growth factor activity. IL-1 proteins are involved in the inflammatory response, being identified as endogenous pyrogens, and are reported to stimulate the release of prostaglandin and collagenase from synovial cells.
-
基因功能參考文獻:
- Based on the available data, C/T genotype of the rs1800587 polymorphism within IL1A gene may be associated with an increased Graves' disease risk. PMID: 29879187
- IL-1 was positively related with increased BMI overweight and obesity PMID: 30070872
- IL-1alpha is detectable in the majority of patients with infrarenal abdominal aortic aneurysms. PMID: 29456054
- Meta-analysis suggests that the IL-1B rs16944 polymorphism is a susceptibility risk factor for febrile seizures in Caucasian and Asian populations. The IL-1B rs1143627, IL-1B rs1143634, and IL-1A rs1800587 polymorphisms are not associated with febrile seizure risk. PMID: 29808330
- The IL-1b+3954 C/T polymorphism significantly increases RAS risk. In addition, the IL-10-1082 G/A polymorphism provided protective effects for RAS in the Asian population PMID: 29641282
- The single nucleotide polymorphism (SNP) of IL-1beta gene (rs3917356G>A) increased the risk of HCC in the recessive model (p<0.001, OR=2.58, 95% CI=1.53-4.33), whereas other SNPs in IL-1alpha and IL-1RA showed no significant association between Hepatocellular carcinoma patients and controls. PMID: 29802240
- our findings proposed an association between IL1A 4-bp ins/del polymorphism and risk of prostate cancer PMID: 29023981
- effect of IL-22 on Intestinal Epithelial Cells responses may not be in inducing CXCL8 by itself, but in enhancing TNF-alpha- and IL-1-induced CXCL8 secretion to augment the contribution of IECs to local inflammatory responses. PMID: 28656529
- Our pilot study demonstrated a correlation between the individual genetic inflammatory profile and the efficacy of the platelet rich plasma treatment in males PMID: 29228441
- the present study was intended to determine whether single-nucleotide polymorphisms (SNPs) in the IL-1 gene cluster are also associated with periodontal disease in a Linkage disequilibrium analysis PMID: 29577711
- No significant difference was seen in mRNA levels among different promoter genotype for IL1A in SCA3 patients vs. controls, except a previously reported higher level in those with the IL1A*T allele. These patients also showed an earlier age of onset than those homozygous for IL1A*C. PMID: 27246313
- Obesity was associated with higher expression of NILCO molecules (Notch-IL1-leptin) in type II endometrial cancer. PMID: 28659656
- This meta-analysis with 2,174 patients with chronic periodontitis and 1, 756 controls evidenced the -889 C/T polymorphism is associated to risk of development of chronic periodontitis with no significant value to heterogeneity to allelic evaluation PMID: 27918732
- through IL-1alpha production, airway epithelial cells induce a pro-inflammatory lung fibroblast phenotype that is further enhanced with cigarette smoke extract exposure in COPD, suggesting an aberrant epithelial-fibroblast interaction in COPD PMID: 27418555
- our study has described the association between rs3783550 (IL-1A), rs3783546 (IL-1A) and rs2853550 (IL-1B) and AS risk and between a new haplotype, "TCG", of rs3783550, rs3783546 and rs2853550 and AS in Chinese Han population. PMID: 28423679
- Unicystic Ameloblastoma patients with high IL-1alpha expression in the lesion responded better to marsupialization than those in whom the expression of the protein was low, and therefore show a greater reduction of the cystic space after marsupialization. PMID: 29419674
- In conclusion, the analyzed IL1A -889 C>T, IL1B +3954 C>T, and IL6 -174 G>C polymorphisms may be associated with the occurrence and development of human cytomegalovirus infection among studied patients. PMID: 28151075
- Lipid apheresis suppresses the expression of IL-1alpha, IL-6 and TNF-alpha mRNA in patients with dyslipidaemias. PMID: 29096839
- results suggest a role for prostatic expression of TGF-B, IL-1a, TGFBRI and TGFBRII as prognostic markers for prostate cancer. The rational combination of novel agents directed toward the inactivation of TGF-B, IL-1a, TGFBRI and TGFBRII could disrupt complementary tumor cell proliferation pathways. PMID: 27527810
- There were no significant differences in GE area of infertile and fertile women. C-C motif chemokine 11 (P=0.048), TGFalpha (P=0.049), IFNgamma (P=0.033) and interleukin-1 alpha (P=0.047) were significantly elevated in uterine lavage from infertile women <35years compared to fertile but not in women 35years PMID: 27525354
- The authors' findings suggest that IL-1a rs3783553 polymorphism may modulate the risk of squamous cell carcinoma of the oropharynx recurrence in patients, particularly for patients with HPV16-positive tumors. PMID: 27121322
- IL-1alpha released from necrotic corneal epithelial cells may trigger inflammatory responses at the ocular surface, including cytokine production and barrier disruption. PMID: 28725984
- Based on current meta-analysis, we indicated that there is lack of association between the three SNPs of IL-1 and primary open-angle glaucoma. PMID: 29179746
- results showed that IL-1A -889C/T (rs1800587) was associated with systemic sclerosis susceptibility in the Chinese population PMID: 27098064
- Reconstitution of ST2 (IL-1R4) specific for IL-33 activity; no suppression by IL-1Ra though a common chain IL-1R3 (IL-1RAcP) shared with IL-1. PMID: 27031441
- A SNP in IL1A were associated with keratoconus in Chinese Han patients PMID: 26200829
- these findings highlight the interaction between IL-6 and IL-1alpha to generate an inflammatory microenvironment in driving (PSMA,PSA) prostate clones PMID: 27451139
- MSCs primed with IL-1alpha or IL-1beta showed increased secretion of G-CSF, which was blocked by IL-1Ra. PMID: 28412968
- rs3783553 ins/ins genotype may increase the susceptibility to ischemic stroke, possibly by interrupting the binding site of miR-122 and miR-378 PMID: 29145255
- The abnormalities in hormonal/biochemical parameters detected in Turkish polycystic ovary syndrome patients may be related with IL-6 gene polymorphism rather than IL-1A. PMID: 28019133
- Major D allele of IL-1A (I/D) gene polymorphism is associated with NAFLD in the Egyptian population PMID: 28627263
- Interleukin-1alpha induces release of interleukin-8 by human bronchial epithelial cells PMID: 28078769
- the results indicate prominent antagonistic effects of IL-1alpha on TGF-beta regulated interferon signaling, as well as on a wide variety of other genes and pathways in fibroblasts. PMID: 26629874
- IL1A polymorphism rs1800587 is associated with chronic pain in patients with sickle cell disease. PMID: 27883292
- Data indicate that interleukin 1alpha (IL-1alpha) propiece can activate NF-kappa B (NFkappaB) and Sp1 transcription factor (SP1). PMID: 28152513
- cytokines of the IL-1 family play an important role in homeostatic as well as "emergency" hematopoiesis and are involved in the pathogenesis of several myeloid and lymphoid hematological malignancies. PMID: 28483765
- These results suggest that IL-1alpha enhances the translocation of TRPA1 to the plasma membrane via the activation of Erk in A549. PMID: 28629997
- Single Nucleotide Variants of Candidate Genes in Aggrecan Metabolic Pathway Are Associated with Lumbar Disc Degeneration and Modic Changes PMID: 28081267
- Polymorphisms of Il1a were not significantly associated with bipolar I disorder in Iranian patients. PMID: 28129679
- This meta-analysis suggested that the IL-1alpha (+889C/T) polymorphism is significantly associated with risk of Intervertebral Disc Degeneration, especially in Caucasian populations. PMID: 27253397
- we show that IL-1 induces robust p38a activation both in the nucleus and in the cytoplasm/membrane.Following stimulation, p38a activity returns to a basal level in absence of receptor degradation. While nuclear pulse is controlled by MKP1 through a negative feedback to pp38, its basal activity is controlled by both TAB1 and MKP1 through a positive feedback loop. PMID: 27314954
- Key aspects of IL-1alpha biology and regulation, especially its emerging importance in the initiation and maintenance of inflammation that underlie the pathology of many human diseases, are reviewed. Review. PMID: 27434011
- This study demonstrates that the rs3783553 polymorphism may be involved in susceptibility to endometrial cancer. The II genotype seems to be a protective factor for endometrial cancer in Chinese Han women. PMID: 27136893
- Circulating Il1a levels were not altered in nonalcoholic fatty liver disease. PMID: 27493109
- The IL-1alpha rs1800587 polymorphism demonstrated a significant association with the childhood type 1 diabetes mellitus risk. PMID: 27706611
- The percentage of the -889 promotor SNP was similar but not overlapping in all the groups: periodontal disease only (40.8%), PD plus rheumatoid arthritis (50.2%), and PD plus NIDDM (46%). PMID: 27655512
- this study shows that IL-1a gene variants are not associated with susceptibility to juvenile idiopathic arthritis in Iranian population PMID: 27717726
- IL1 and IL6 are important components of the tumor microenvironment, displaying multiple functions. These cytokines take part at all stages of oncogenesis: from initiation to tumor, invasion, and metastasis of already established malignant and mutant epithelial cells. [Review] PMID: 27260388
- IL-1genotype has no effect on Antibiotic Resistance on Helicobacter pylori Eradication. PMID: 27221874
- Genetic polymorphisms in the IL1A, IL1B, IL2 and IL6 genes are not genetic modulators of depression in a cohort of Polish subjects. PMID: 26934083
顯示更多
收起更多
-
亞細胞定位:Cytoplasm. Secreted.
-
蛋白家族:IL-1 family
-
數據庫鏈接:
Most popular with customers
-
-
Phospho-YAP1 (S127) Recombinant Monoclonal Antibody
Applications: ELISA, WB, IHC
Species Reactivity: Human
-
-
-
-
-
-